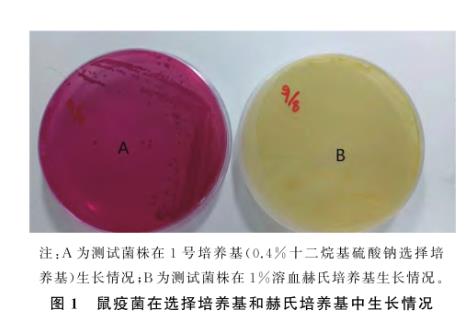
鼠疫耶爾森氏菌在3種選擇培養(yǎng)基生長(zhǎng)能力的測(cè)定——材料與方法

本試驗(yàn)致病菌最終鑒定為戴氏西地西菌。本文制作了它的生長(zhǎng)曲線,為其后面的研究打下了基礎(chǔ)。并利用用全自動(dòng)微生物分析儀進(jìn)行藥敏分析,結(jié)果分離出幾種高度敏感的 ...
歡迎來(lái)到BioSense網(wǎng)站!
歡迎來(lái)到BioSense網(wǎng)站!

本試驗(yàn)致病菌最終鑒定為戴氏西地西菌。本文制作了它的生長(zhǎng)曲線,為其后面的研究打下了基礎(chǔ)。并利用用全自動(dòng)微生物分析儀進(jìn)行藥敏分析,結(jié)果分離出幾種高度敏感的 ...

?摘要:本試驗(yàn)旨在從患病鯽魚的鰓、腎、肝、胰臟等病灶部位分離病原菌,并對(duì)其進(jìn)行鑒定。采用革蘭染色的方法觀察其為短桿狀、呈單雙排列的革蘭陰性菌,利用丹麥 ...

本文將通過(guò)給小鼠氣管注射一種鮑曼不動(dòng)桿菌耐藥菌株來(lái)構(gòu)建體內(nèi)感染模型,并進(jìn)行相關(guān)案例分析。將處于對(duì)數(shù)生長(zhǎng)期的鮑曼不動(dòng)桿菌于OD600 nm處檢測(cè)菌液濃度 ...

本研究揭示了干旱對(duì)高寒草原微生物群落和生態(tài)功能的深遠(yuǎn)影響,為全球氣候變化背景下的生態(tài)系統(tǒng)管理提供了重要啟示。首先,微生物網(wǎng)絡(luò)復(fù)雜性與土壤多功能性密切相 ...

?摘要:本研究探討了干旱對(duì)青藏高原高寒草原微生物共現(xiàn)網(wǎng)絡(luò)和土壤功能的影響。干旱顯著降低了細(xì)菌、真菌和原生生物的網(wǎng)絡(luò)復(fù)雜性(如節(jié)點(diǎn)數(shù)、連通性等)和穩(wěn)定性 ...

鼠疫菌株在1號(hào)培養(yǎng)基經(jīng)28℃培養(yǎng)24 h即可生長(zhǎng)發(fā)育成熟,菌落呈玫紅色,具備鼠疫菌典型結(jié)構(gòu)(菌落花邊大,中央顆粒粗糙),變形桿菌、大腸埃希氏菌及革蘭氏 ...
本研究根據(jù)鼠疫菌培養(yǎng)特性,在基礎(chǔ)培養(yǎng)基中加入可以刺激鼠疫菌生長(zhǎng)的生化試劑和抑制變形桿菌及革蘭氏陽(yáng)性菌的試劑,研制出2種選擇敏感培養(yǎng)基(1%枸椽酸鈉選擇 ...

本次研究結(jié)果顯示,亞胺培南、鹽酸小檗堿兩種藥物聯(lián)合使用時(shí),兩者的藥物濃度均影響減低,鹽酸小檗堿均值從261.00μg/mL降至8.75μg/mL,亞胺 ...

選用棋盤微量稀釋法檢實(shí)施藥物同時(shí)應(yīng)用作用。采用稀釋度為9個(gè),最高濃度使其MIC的4倍,實(shí)施依次倍比稀釋,具體倍比濃度為1、1/2、1/4、1/8、1/ ...

既往研究發(fā)現(xiàn),大部分抑菌的中藥對(duì)細(xì)菌的生長(zhǎng)和蛋白譜的表達(dá)均有影響,本試驗(yàn)也獲得了相似的結(jié)果。在不同濃度巴西蘇木素作用下,CRABA的生長(zhǎng)受到明顯抑制, ...